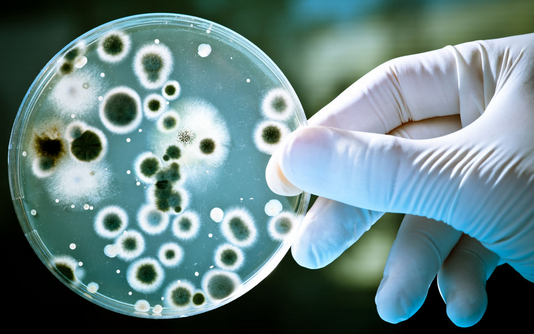
科氏葡萄球菌解脲亚种

万千商家帮你免费找货
0 人在求购买到急需产品
- 详细信息
- 文献和实验
- 技术资料
- 保存条件:
2-8℃
- 保质期:
斜面菌种:1-2个月。冻干菌种:5-10年
- 英文名:
Staphylococcus epidermidis
- 库存:
10
- 供应商:
泽叶生物
- 规格:
冻干粉一支
科氏葡萄球菌解脲亚种细菌菌群、菌属、菌种、菌株等是细菌分类命名的重要名词,在描述细菌时通常用到这些概念,因此有必要了解掌握这些基本概念。
(1) 菌群:由多种细菌混合组成的相对稳定的细菌群体,具有某些共同性状。如大肠菌群包括大肠杆菌、产气肠细菌及他们之间的过渡类型。
(2) 菌属:菌种的上一级分类,通常性状相近、亲缘关系密切的若干菌种组成一个菌属,如芽孢杆菌属、葡萄球菌属、乳杆菌属等。
(3) 科氏葡萄球菌解脲亚种:是细菌最基本的分类单位,通常指表型特征相似、亲缘关系接近的一类细菌群体,与同属内其他种有着明显差异;当涉及到细菌保存时,菌种是指细菌的种子(用来长期保存)资源。
(4) 菌型:同一菌种的不同细菌,在某些方面存在较小差异的为同一菌型,通常一个菌种内的细菌可以分为多种不同的菌型。
(5) 菌株:由一个独立分离的单细胞系培养而成的纯遗传型群体及其一切后代,一种微生物的每一个不同来源的纯培养物均可称为该菌种的一个菌株。
科氏葡萄球菌解脲亚种培养及打管说明
1、安瓿瓶开封:用浸过75%酒精的脱脂棉擦净安瓿管,用火焰加热其顶端,滴少量无菌水至加热顶端使之破裂,用锉刀或者镊子敲下已破裂的安瓿管顶端。
2、菌株恢复培养:用无菌吸管吸取0.3--0.5ml适宜的液体培养基,滴入安瓿管内,轻轻振荡,使冻干菌体溶解呈悬浮状。吸取全部菌体悬浮液,移植于1-2支建议的培养基试管中,并在建议的条件下培养。
3、注意事项:菌种活化前,请将安瓿管保存在6-10℃的环境下,某些菌种经过冷冻干燥保存后,延迟期较长,需要连续两次继代培养才能正常生长
4、复苏后的菌种在传1-2代后使用。
5、暂不启开的安瓿及复苏后需保藏的斜面应于4℃中保藏。
科氏葡萄球菌解脲亚种特别注意事项
l、微生物菌种应保藏于低温、清洁和干燥的地方,室温放置时问过长会导致菌种衰退;
2、菌种操作应在无菌条件下进行,防止杂菌污染:
3、斜面菌种保藏时间通常为1-2个月,应根据菌种状况及时转接;冻干菌种保藏时间通常为5~10年;
4、菌种使用过程中如出现杂菌污染或菌种生产性能下降,应及时与我们销售联系或更换新的菌种。
风险提示:丁香通仅作为第三方平台,为商家信息发布提供平台空间。用户咨询产品时请注意保护个人信息及财产安全,合理判断,谨慎选购商品,商家和用户对交易行为负责。对于医疗器械类产品,请先查证核实企业经营资质和医疗器械产品注册证情况。
文献和实验Staphylococcus cohnii cohnii 科氏葡萄球菌科氏亚种 Staphylococcus cohnii urealyticum 科氏葡萄球菌解脲亚种 Staphylococcus epidermidis 表皮葡萄球菌 Staphylococcus equorum 马胃葡萄球菌 Staphylococcus gallinarum 鸡葡萄球菌 Staphylococcus haemolyticus 溶血葡萄球菌 Staphylococcus hominis 人葡萄球菌
注:#描述性鉴定如纯培养报告:革兰×性×菌生长;如混合菌生长报告:革兰×性×菌和革兰×性×菌混合生长或混杂的革兰×性菌生长。 △如一种菌明显占优势(多于其他菌种10倍以上或>104cfu/ml),则进行鉴定和药敏,而其他非优势菌株(<104cfu/ml)则进行描述性鉴定。对于阴道菌群(乳杆菌属和阴道加德纳菌等)和皮肤菌群(除腐生葡萄球菌以外的凝固酶阴性葡萄球菌,革兰阳性芽孢杆菌、除解脲棒杆菌和F1-群棒杆菌以外的棒状
Actinomyces naeslundii 内氏放线菌 Actinomyces neuii anitratus 纽氏放线菌无硝亚种 Actinomyces neuii neuii 纽氏放线菌纽氏亚种 Actinomyces neuii radingae 纽氏放线菌罗亚种 Actinomyces neuii turicensis 纽氏放线菌图列茨亚种 Actinomyces odontolyticus 龋齿放线菌
技术资料暂无技术资料 索取技术资料